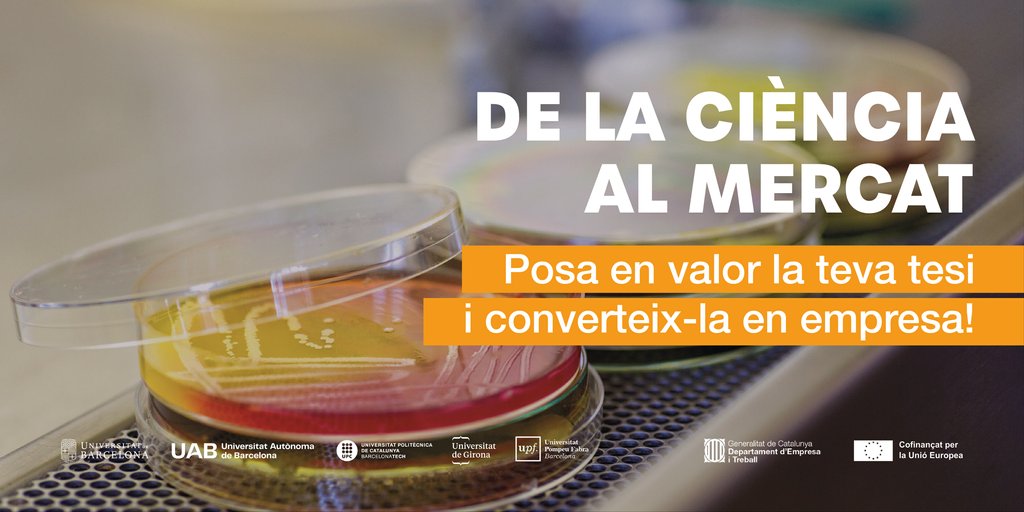
StartUB! Universitat de Barcelona tweet media

Sabitlenmiş Tweet

La #UniBarcelona deixa de publicar a X.
👉🏼 Aquesta decisió, aprovada pel Consell de Direcció, afecta tots els perfils institucionals d’X de la Universitat, que aturaran l’activitat i quedaran inactius.
Llegeix el comunicat 👉 web.ub.edu/web/actualitat…

Català